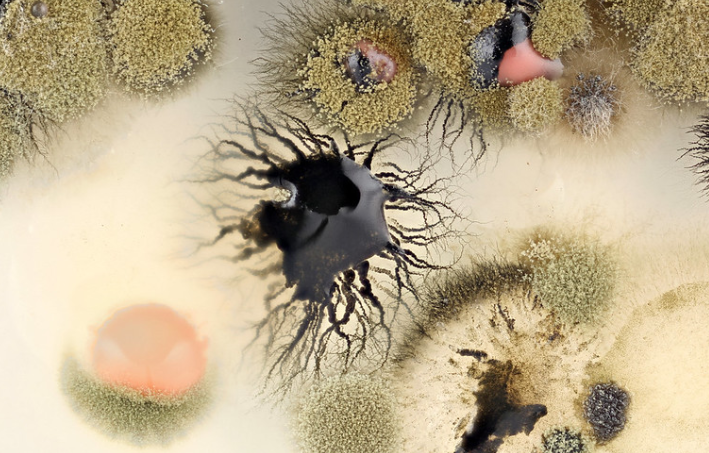

1986년 4월 26일, 체르노빌 원자력 발전소에서 대규모 폭발 사고가 발생했습니다.
이 사건으로 인해 이 지역은 극도로 높은 방사선에 오염되었으며, 생명이 살아갈 수 없는 땅이 되어버렸죠.
그런데 생명이라는 것은 참 대단하고 신기합니다.
이렇게 방사선에 심각하게 오렴된 곳에서도 어떻게든 살아갈 방법을 찾아내니까 말입니다.
사고로부터 5년이 지난 1991년, 과학자들은 원자로의 벽에서 자라나고 있던 균을 발견했습니다.
발견 당시 이 균류는 방사선에 내성을 가지고 있었으며, 심지어 방사선을 먹으면서 자라나고 있었습니다.
방사선을 이용해 살아남는 방법을 스스로 찾아낸 겁니다.

클라도스포리움 스패로스페르뭄(Cladosporium sphaerospermum)이라는 이름의 이 균은 인간의 피부를 검게 만드는 색소인 멜라닌을 아주 많이 가지고 있었는데요.
이러한 대량의 멜라닌을 이용해 해로운 방사선을 흡수한 뒤 다시 이것을 화학 에너지로 바꾸고 있었습니다.
마치 식물이 광합성에 의해 이산화탄소와 엽록소를 산소와 포도당으로 바꾸는 것과 비슷하다고 할 수 있죠.
이러한 과정을 방사성 합성(radiation synthesis)이라고 합니다.
현재 과학자들은 이러한 균의 특성을 이용해 우주인들을 위한 강력한 보호막을 개발할 생각을 하고 있습니다.

이미 국제 우주 정거장(ISS)에서 우주 방사선에 대한 균의 반응 실험이 예전부터 진행되어 오고 있는데요.
그 동안의 실험 결과에 따르면, 이 균을 이용해 2mm정도의 얇은 층을 만들면 우주 방사선의 2%를 차단하거나 흡수할 수 있다는 것을 확인했습니다.
우주 방사선에는 태양에서 나오는 자외선, X선, 감마선 뿐만 아니라, 태양계 밖에서 발생하는 은하 우주선(galactic cosmic rays)이라고 불리는 초고속 아원자 입자들도 많이 포함되어 있습니다.
이러한 우주 방사선에 노출되어 DNA 손상이 반복되면, 암 발생과 방사선 중독에 의해 사망으로 이어질 수도 있죠.
미래에 이루어질 화성 유인 탐사에서 우주안들은 이러한 우주 방사선에 대량으로 노출될 수 있습니다.
하지만 이 균을 잘 이용하면, 이러한 강력한 우주 방사선으로부터 우주인들을 안전하게 지켜줄 수 있게 될겁니다.
과학자들은 균의 두께를 21cm까지 만들 수 있게 된다면, 우주 방사선을 100% 막아낼 수 있을 것으로 것으로 생각하고 있는데요.
두께가 좀 있기 때문에 우주복에 적용되기 보다는 화성이나 달 탐사에 이용할 수 있는 기지 건설에 사용될 수 있습니다.
무게도 고작 몇 그램 밖에 안되서 단열벽 안에 넣어 물만 공급해주면 매우 훌륭한 방사선 차폐기 역할을 해줄 수 있을 겁니다.
참고로 물은 화성의 극지방에 있는 얼음을 이용하면 됩니다.

또한 이 균은 자신의 복사본을 만들어내는 방식으로 스스로를 치유할 수도 있습니다.
즉, 강력한 방사선에 의해 손상을 입더라도 며칠만 지나면 다시 성장해서 원래 상태로 돌아갈 수 있다는 거죠.
현재 이용되고 있는 납이나 물을 이용한 차폐 방식은 방사선을 막아주긴 하지만 너무 무겁고 비용이 많이 든다는 문제가 있습니다.
이 균에 대한 연구가 꾸준히 이루어진다면, 더욱 저렴한 비용과 높은 안전성으로 달과 화성에 기지를 건설할 수 있게 될겁니다.
어쩌면 그 이전에 우리의 실생활에서 사용될 수도 있습니다.
NASA는 이 균의 방사선 흡수력을 추출하여 휴대용 제품에 응용할 수 있는 아이디어를 생각하고 있는데요.
나중에는 지금보다 더욱 강력한 자외선 차단 크림이나 완전히 새로운 방사선 차단 크림이 등장하게 될지도 모릅니다.
현재 과학자들은 국제 우주 정거장에서 멜라닌 색소만을 이용해 우주 방사선을 막을 수 있는지에 대한 실험을 진행하고 있습니다.
※ 본 내용에서 언급한 방사선은 이온화 방사선입니다.
이온화 방사선은 물질을 통과할 때에 이온화를 일으키는 엑스선, 알파선, 감마 입자, 양성자, 중성자 등의 입자를 말합니다.
[실험 방법 및 주요 결과]
Ionizing irradiation changed the electron spin resonance (ESR) signal of melanin, consistent with changes in electronic structure. Irradiated melanin manifested a 4-fold increase in its capacity to reduce NADH relative to non-irradiated melanin. HPLC analysis of melanin from fungi grown on different substrates revealed chemical complexity, dependence of melanin composition on the growth substrate and possible influence of melanin composition on its interaction with ionizing radiation. XTT/MTT assays showed increased metabolic activity of melanized C. neoformans cells relative to non-melanized cells, and exposure to ionizing radiation enhanced the electron-transfer properties of melanin in melanized cells. Melanized Wangiella dermatitidis and Cryptococcus neoformans cells exposed to ionizing radiation approximately 500 times higher than background grew significantly faster as indicated by higher CFUs, more dry weight biomass and 3-fold greater incorporation of 14C-acetate than non-irradiated melanized cells or irradiated albino mutants. In addition, radiation enhanced the growth of melanized Cladosporium sphaerospermum cells under limited nutrients conditions.
2020/01/30 - [지구・ 생명] - 티벳 빙하에서 발견된 고대의 바이러스
티벳 빙하에서 발견된 고대의 바이러스
1만 5000년 전, 티베트 고원의 물이 얼어붙어 빙하가 되었습니다. 이 때 수많은 미생물들이 이 얼음속에 갇히게 되었죠. 대부분은 살아남지 못했지만, 얼마전 과학자들은 이 얼음속에서 지금까지
livelive.tistory.com
2019/05/03 - [인류・ 역사] - 인류를 끝장낼 수 있었던 무서운 재앙 5가지
인류를 끝장낼 수 있었던 무서운 재앙 5가지
영화 "2012" 또는 "아마겟돈"을 본 사람이라면, 인류의 멸종 상황을 어렵지 않게 상상해볼 수 있을 겁니다. 예를 들어, 운석의 공격이라든지, 또는 인류가 만들어낸 핵 때문일 수도�
livelive.tistory.com
2020/07/30 - [자연・우주] - 태양 내부에서 만들어진 희귀 유령 입자가 처음으로 감지되었다.
태양 내부에서 만들어진 희귀 유령 입자가 처음으로 감지되었다.
과학자들은 태양에서 나오는 아주 희귀한 유령 입자를 발견했습니다. 이 입자는 태양의 내부에서 독특한 융합 과정에 의해 만들어질 것으로 예측되었던 입자인데요. 이 입자의 이름은 "CNO 중성�
livelive.tistory.com
| 죽을 때 비명을 질러 동료에게 위험을 알리는 세균 발견 (1) | 2020.09.04 |
|---|---|
| 어마어마하게 긴 목을 가지고 있는 고대의 파충류 (0) | 2020.08.11 |
| 과학자들은 우연하게 새로운 물고기를 만들어냈습니다. (0) | 2020.07.25 |
| 과학자들은 지구 깊은 곳에서 미확인 구조물을 발견했습니다. (0) | 2020.06.17 |
| 여자의 난자는 모르는 남자의 정자도 유혹합니다. (1) | 2020.06.11 |